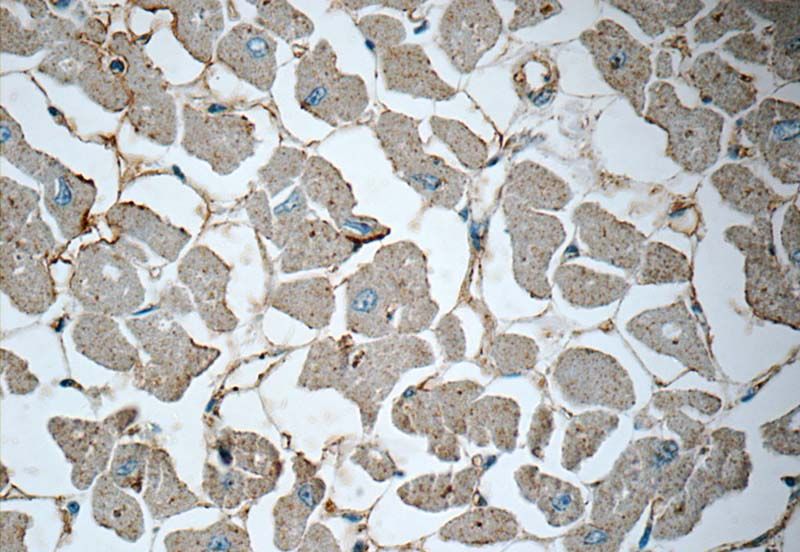
Immunohistochemistry of paraffin-embedded human heart tissue slide using Catalog No:114690 (RENIN-RECEPTOR, ATP6AP2 Antibody) at dilution of 1:50 (under 40x lens)

-
Product Name
Renin receptor,ATP6AP2 antibody
- Documents
-
Description
Renin receptor,ATP6AP2 Rabbit Polyclonal antibody. Positive IHC detected in human heart tissue. Positive WB detected in mouse eye tissue, human retinal pigment epithelium tissue, Y79 cells. Observed molecular weight by Western-blot: 45-47 kDa
-
Tested applications
ELISA, WB, IHC
-
Species reactivity
Human,Mouse,Rat; other species not tested.
-
Alternative names
APT6M8 9 antibody; ATP6AP2 antibody; ATP6IP2 antibody; ATP6M8 9 antibody; CAPER antibody; ELDF10 antibody; HT028 antibody; M8 9 antibody; MRXE antibody; MSTP009 antibody; N14F antibody; PRR antibody; PSEC0072 antibody; Renin receptor antibody; RENIN RECEPTOR antibody; ATP6AP2 antibody; Renin/prorenin receptor antibody; V ATPase M8.9 subunit antibody; XMRE antibody
-
Isotype
Rabbit IgG
-
Preparation
This antibody was obtained by immunization of Renin receptor,ATP6AP2 recombinant protein (Accession Number: BC010395). Purification method: Antigen affinity purified.
-
Clonality
Polyclonal
-
Formulation
PBS with 0.1% sodium azide and 50% glycerol pH 7.3.
-
Storage instructions
Store at -20℃. DO NOT ALIQUOT
-
Applications
Recommended Dilution:
WB: 1:200-1:2000
IHC: 1:20-1:200
-
Validations

WB result from Oscar Alcazar, et al, (Pro)renin receptor is expressed in human retinal pigment epithelium and participates in extracellular matrix remodeling, Exp Eye Res. 89(5) 638-47 (2009) (PMID:19580809). Eye 45kd.

mouse eye tissue were subjected to SDS PAGE followed by western blot with Catalog No:114690(RENIN-RECEPTOR,ATP6AP2 antibody) at dilution of 1:600

Immunohistochemistry of paraffin-embedded human heart tissue slide using Catalog No:114690 (RENIN-RECEPTOR, ATP6AP2 Antibody) at dilution of 1:50 (under 10x lens)
Immunohistochemistry of paraffin-embedded human heart tissue slide using Catalog No:114690 (RENIN-RECEPTOR, ATP6AP2 Antibody) at dilution of 1:50 (under 40x lens)
-
Background
ATP6AP2, also named as ATP6IP2, CAPER, ELDF10, N14F, ATP6M8-9, Renin receptor and prorenin receptor, is believed to potentiate the renin–angiotensin system (RAS), conferring to prorenin, a likely pathological role at tissue level. The PRR has been identified in the microvascular endothelial cells of the retina, in which it seems to be involved in pathological neovascularization processes. The present study demonstrates for the first time that the PRR is expressed in human ATP6AP2 and suggests a molecular mechanism by which hypertension may exacerbate the pathology of dry AMD. ATP6AP2 functions as a renin and prorenin cellular receptor. It may mediate renin-dependent cellular responses by activating ERK1 and ERK2. By increasing the catalytic efficiency of renin in AGT/angiotensinogen conversion to angiotensin I, it may also play a role in the renin-angiotensin system (RAS). Defects in ATP6AP2 are a cause of mental retardation X-linked with epilepsy (MRXE). (PMID:19580809)
-
References
- Alcazar O, Cousins SW, Striker GE, Marin-Castano ME. (Pro)renin receptor is expressed in human retinal pigment epithelium and participates in extracellular matrix remodeling. Experimental eye research. 89(5):638-47. 2009.
Related Products / Services
Please note: All products are "FOR RESEARCH USE ONLY AND ARE NOT INTENDED FOR DIAGNOSTIC OR THERAPEUTIC USE"
